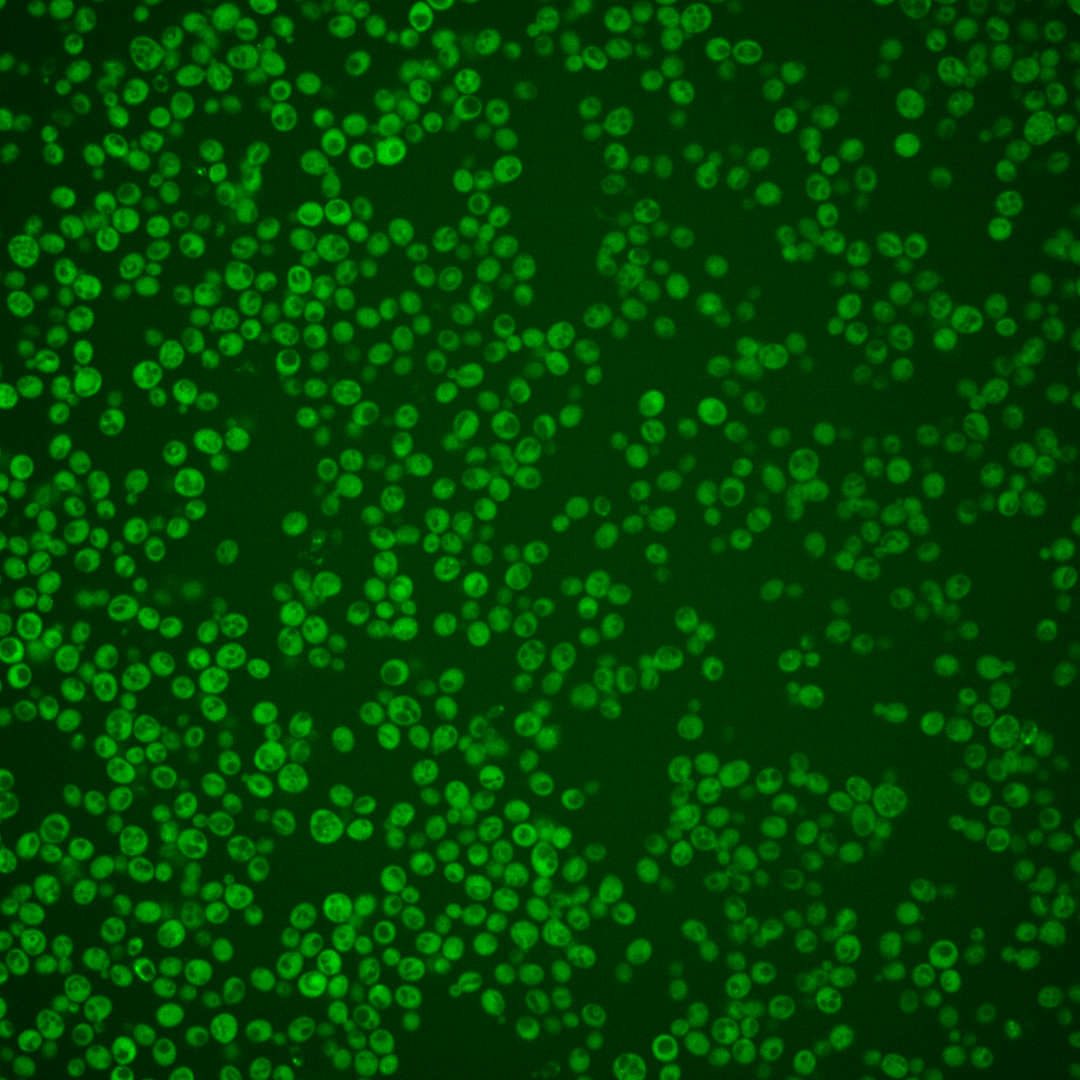
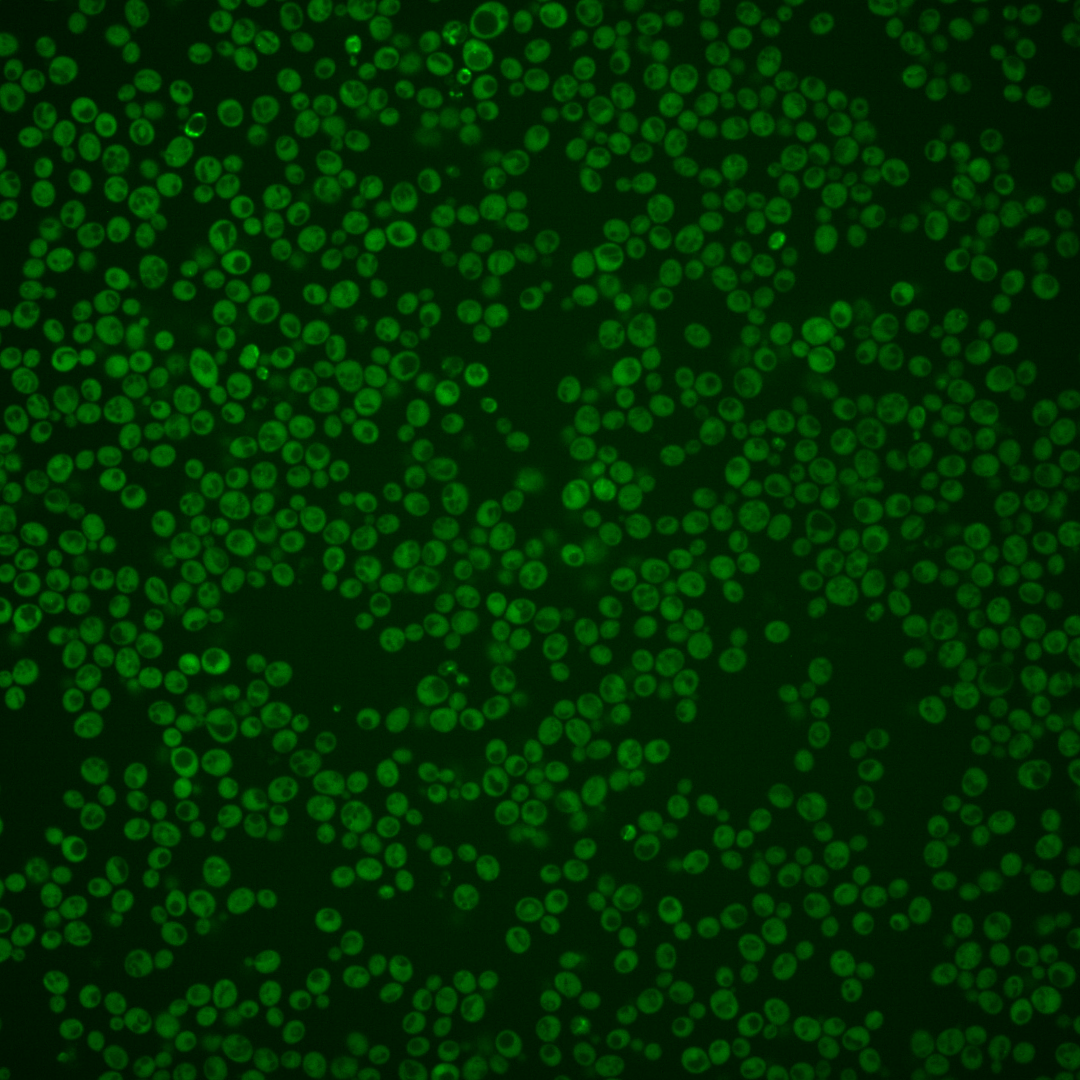
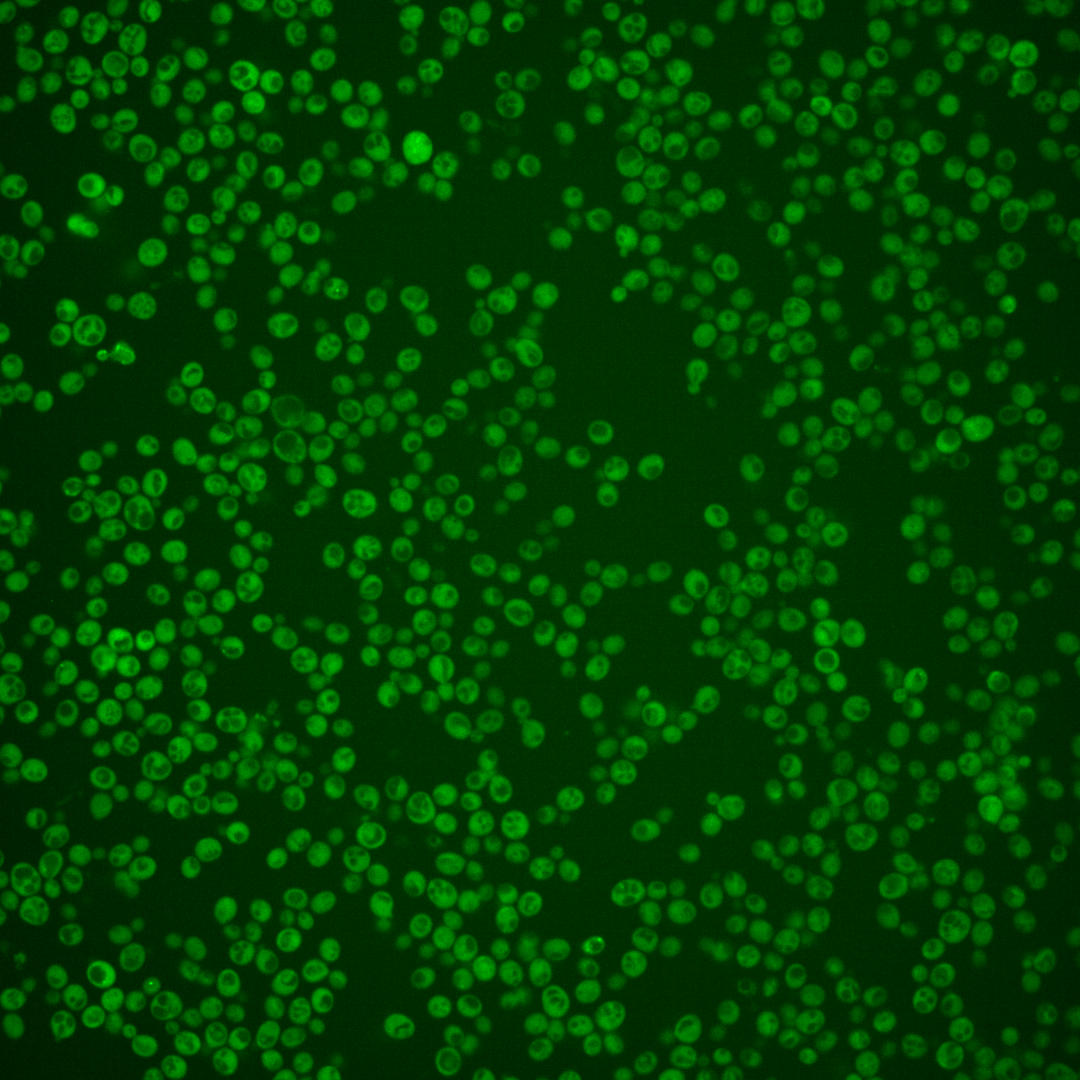
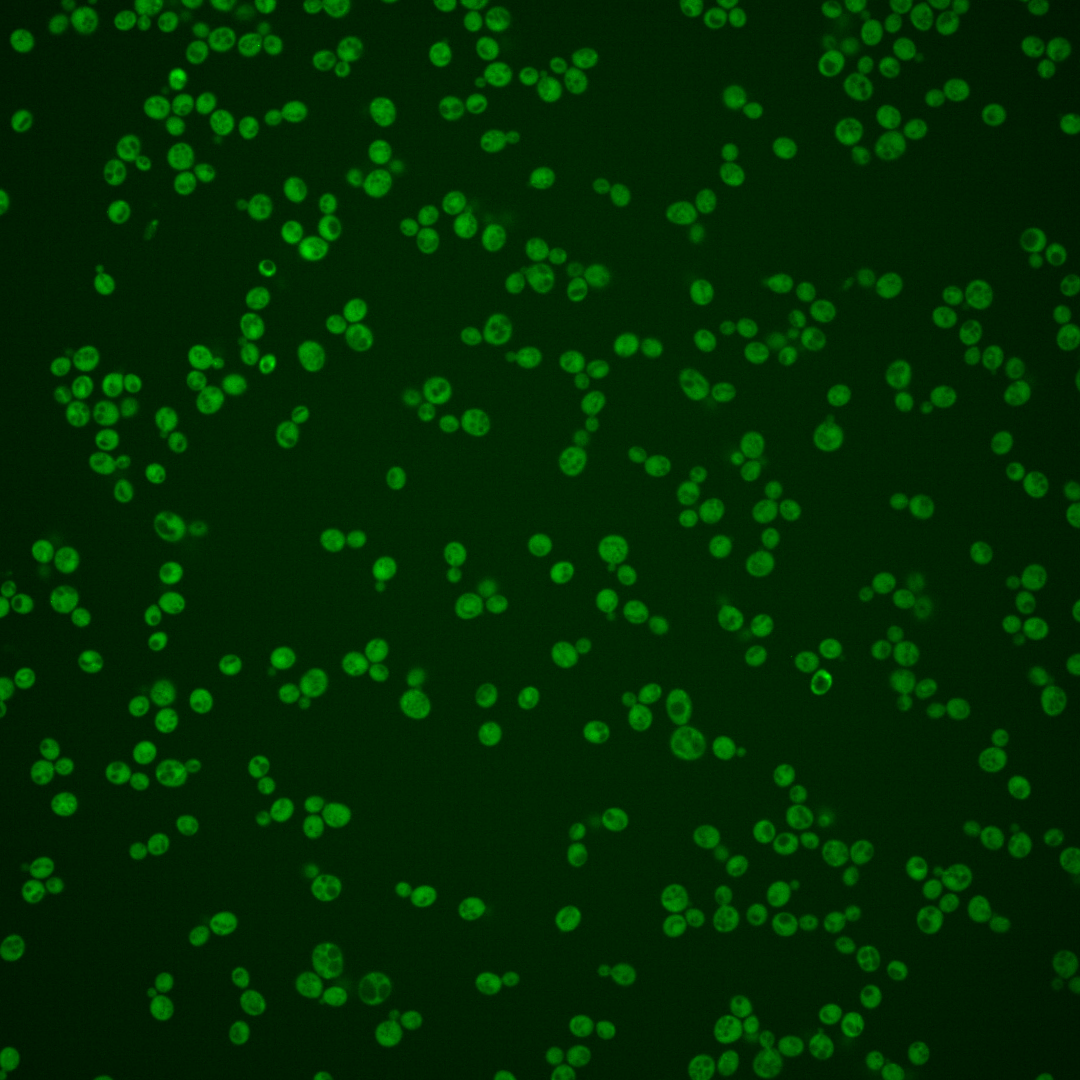
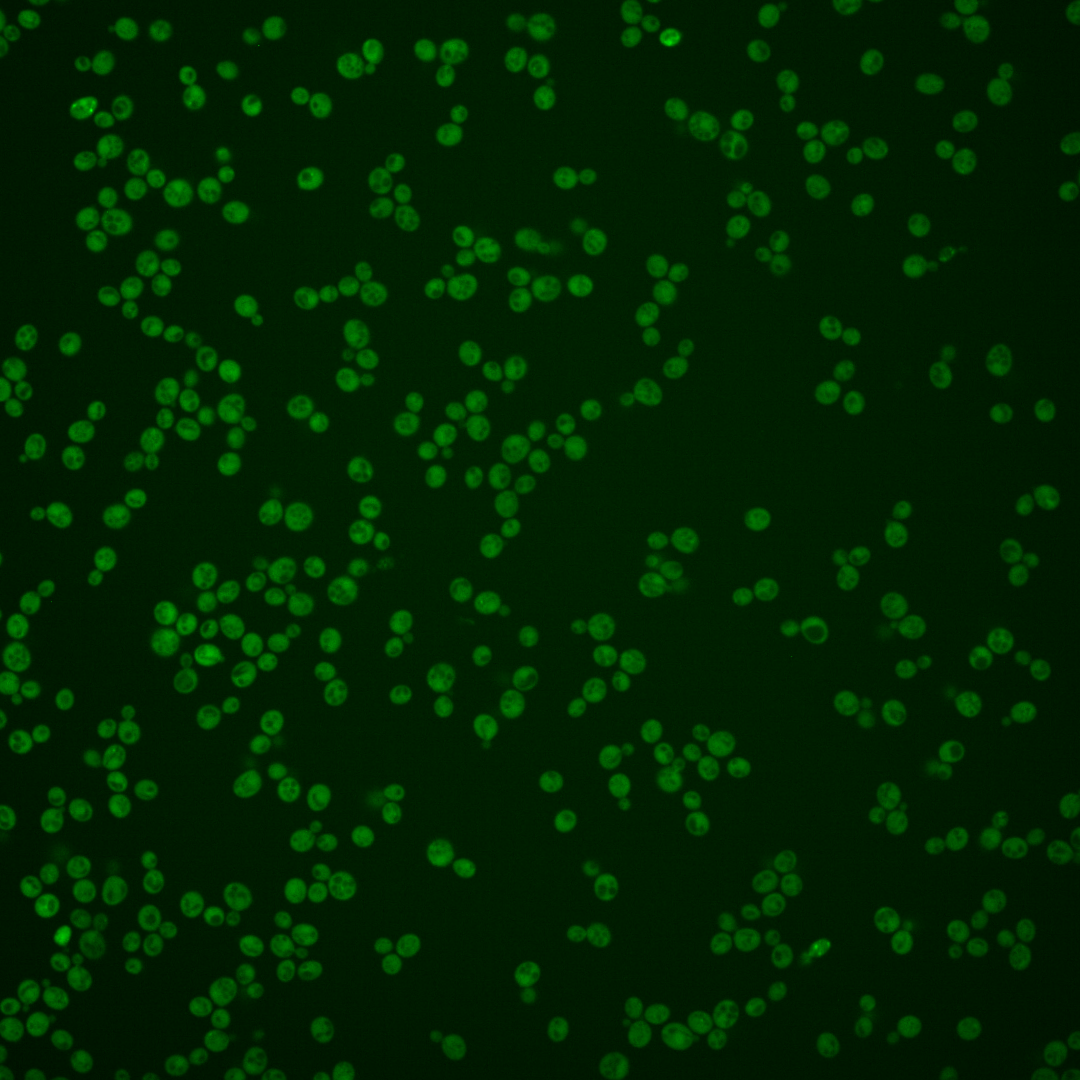
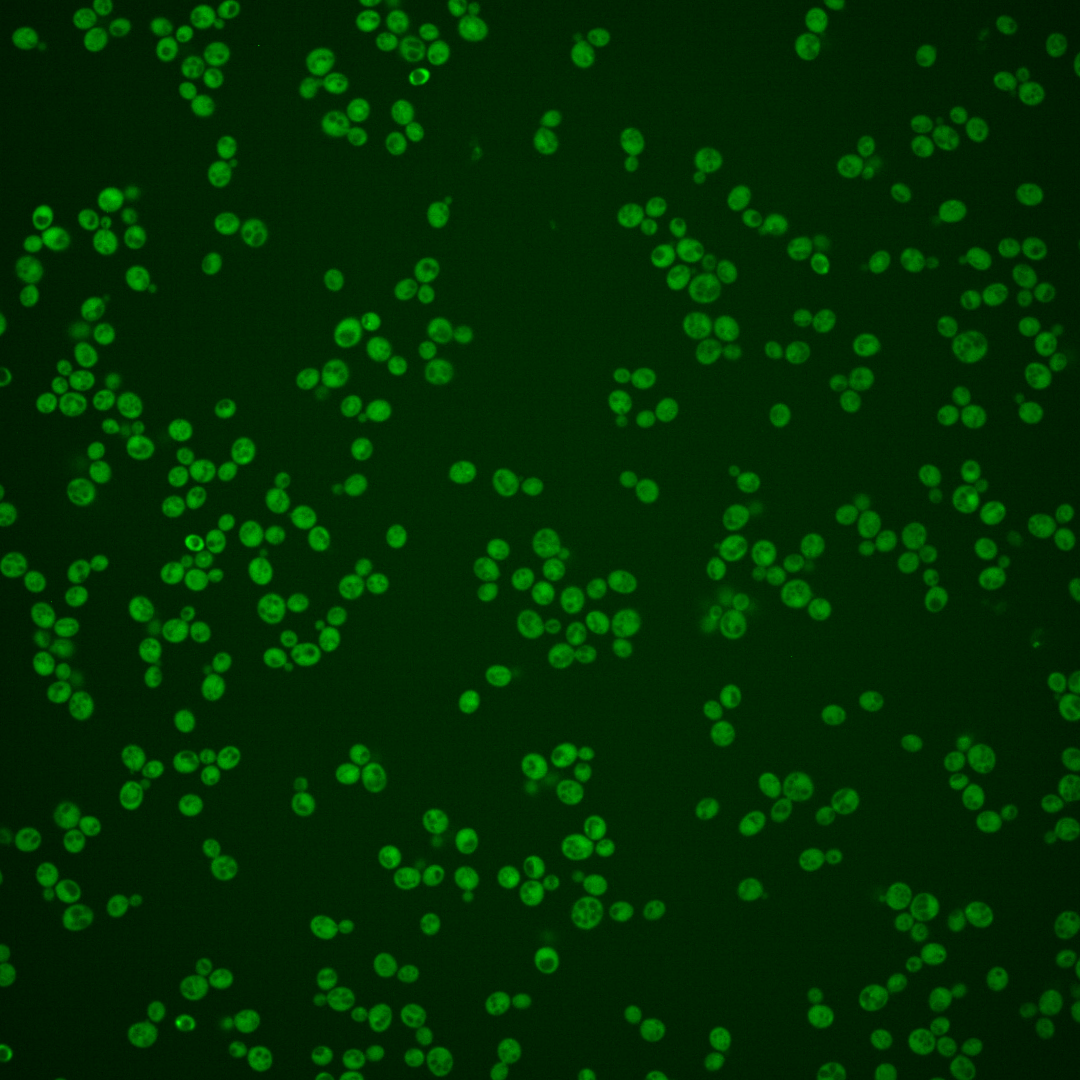
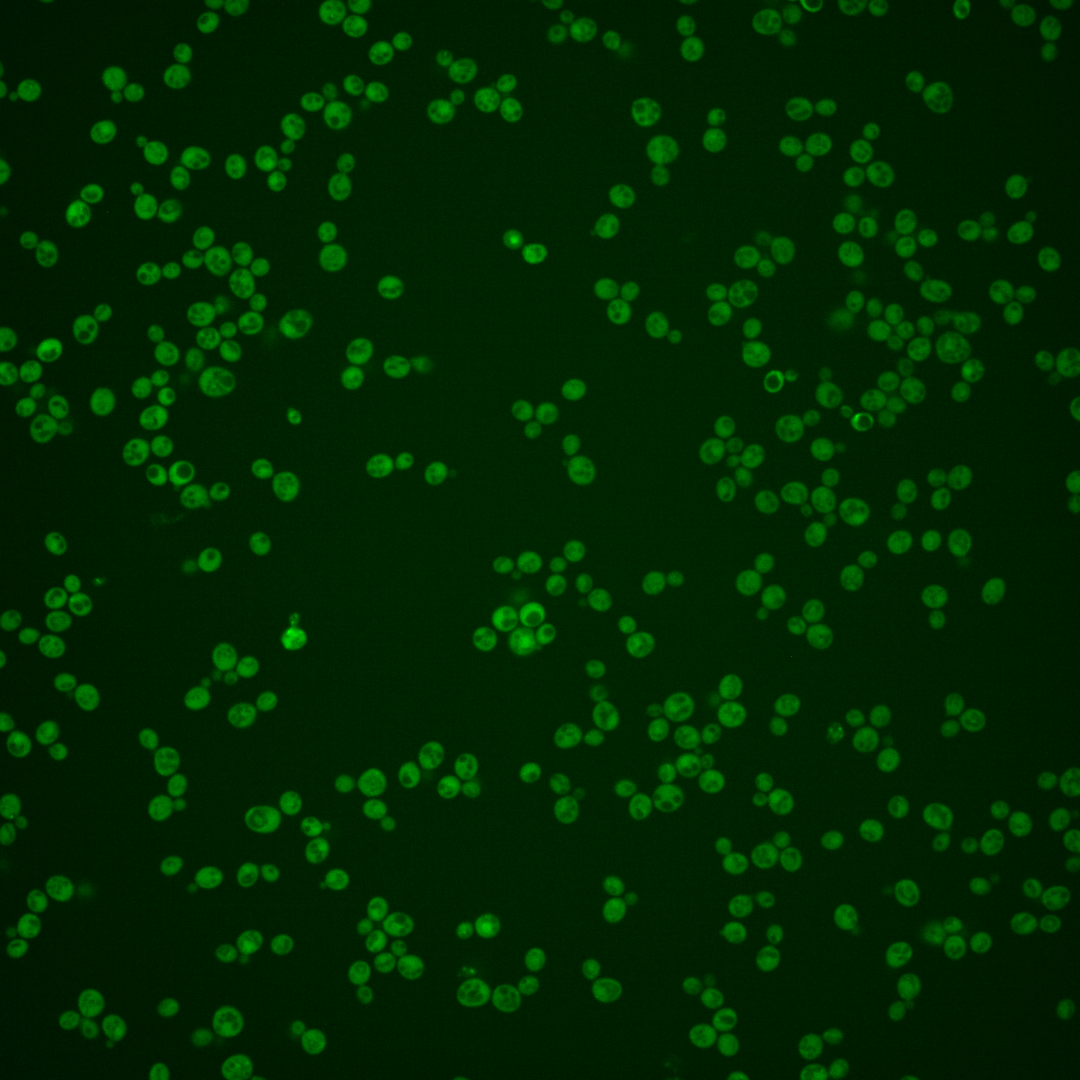

| Standard name | |
|---|---|
| Human Ortholog | |
| Description | Regulatory subunit of the Atg1p signaling complex; stimulates Atg1p kinase activity; required for vesicle formation during autophagy and the cytoplasm-to-vacuole targeting (Cvt) pathway; contains a HORMA domain required for autophagy and for recruitment of the phosphatidylinositol 3-kinase complex subunit Atg14p to the pre-autophagosomal structure |
Micrographs




















































































Sub-cellular Localization
Yeast GFP Assignment
Protein Abundance
Localization Change
External localization resources
| ensLOC | DeepLoc | |||||||||||||||||||||||
|---|---|---|---|---|---|---|---|---|---|---|---|---|---|---|---|---|---|---|---|---|---|---|---|---|
| Localization | WT1 | WT2 | WT3 | RAP60 | RAP140 | RAP220 | RAP300 | RAP380 | RAP460 | RAP540 | RAP620 | RAP700 | HU80 | HU120 | HU160 | rpd3Δ_1 | rpd3Δ_2 | rpd3Δ_3 | WT1 | WT2 | WT3 | AF100 | AF140 | AF180 |
| Cortical Patches | 1 | 0 | 0 | 9 | 12 | 3 | 3 | 10 | 4 | – | 2 | 6 | 0 | 1 | 1 | 2 | 0 | 0 | 0 | 0 | 0 | 0 | 1 | 2 |
| Bud | 0 | 0 | 4 | 2 | 7 | 9 | 13 | 13 | 9 | – | 10 | 8 | 3 | 1 | 6 | 0 | 0 | 0 | 0 | 0 | 0 | 2 | 2 | 4 |
| Bud Neck | 0 | 0 | 1 | 3 | 2 | 1 | 4 | 5 | 2 | – | 2 | 2 | 0 | 0 | 0 | 0 | 0 | 0 | 1 | 0 | 0 | 0 | 1 | 4 |
| Bud Site | 0 | 0 | 0 | 0 | 0 | 0 | 1 | 0 | 0 | – | 0 | 0 | 0 | 0 | 0 | 0 | 0 | 0 | – | – | – | – | – | – |
| Cell Periphery | 0 | 0 | 2 | 0 | 1 | 0 | 3 | 5 | 1 | – | 4 | 3 | 3 | 1 | 3 | 12 | 9 | 13 | 0 | 0 | 0 | 0 | 0 | 0 |
| Cytoplasm | 167 | 70 | 258 | 196 | 263 | 253 | 382 | 456 | 229 | – | 194 | 252 | 387 | 396 | 476 | 461 | 247 | 243 | 161 | 81 | 238 | 132 | 244 | 281 |
| Endoplasmic Reticulum | 2 | 0 | 2 | 4 | 4 | 5 | 2 | 1 | 11 | – | 8 | 5 | 6 | 4 | 6 | 18 | 2 | 10 | 0 | 0 | 2 | 7 | 18 | 11 |
| Endosome | 0 | 0 | 0 | 3 | 20 | 26 | 30 | 27 | 13 | – | 14 | 17 | 7 | 18 | 20 | 13 | 1 | 4 | 2 | 0 | 1 | 2 | 11 | 11 |
| Golgi | 1 | 0 | 0 | 0 | 0 | 0 | 0 | 0 | 0 | – | 0 | 0 | 0 | 0 | 0 | 2 | 2 | 2 | 0 | 0 | 0 | 0 | 0 | 0 |
| Mitochondria | 4 | 3 | 1 | 1 | 1 | 14 | 33 | 24 | 91 | – | 94 | 47 | 1 | 2 | 1 | 5 | 0 | 0 | 2 | 2 | 7 | 5 | 18 | 13 |
| Nucleus | 0 | 0 | 0 | 2 | 1 | 1 | 1 | 5 | 4 | – | 0 | 2 | 0 | 0 | 2 | 0 | 3 | 1 | 0 | 0 | 0 | 0 | 0 | 1 |
| Nuclear Periphery | 1 | 0 | 0 | 0 | 0 | 0 | 0 | 0 | 0 | – | 1 | 0 | 0 | 0 | 0 | 0 | 0 | 0 | 1 | 0 | 0 | 0 | 1 | 0 |
| Nucleolus | 0 | 0 | 0 | 0 | 0 | 0 | 0 | 0 | 0 | – | 0 | 1 | 0 | 0 | 0 | 1 | 0 | 0 | 0 | 0 | 0 | 0 | 0 | 1 |
| Peroxisomes | 0 | 0 | 0 | 0 | 0 | 1 | 0 | 0 | 2 | – | 0 | 2 | 0 | 2 | 2 | 0 | 0 | 0 | 0 | 0 | 0 | 0 | 0 | 0 |
| SpindlePole | 0 | 0 | 0 | 14 | 35 | 13 | 21 | 48 | 11 | – | 6 | 27 | 1 | 2 | 3 | 2 | 0 | 0 | 0 | 0 | 0 | 0 | 2 | 1 |
| Vac/Vac Membrane | 0 | 0 | 1 | 0 | 11 | 7 | 2 | 9 | 6 | – | 8 | 2 | 0 | 4 | 4 | 27 | 10 | 15 | 0 | 2 | 13 | 17 | 54 | 69 |
| Unique Cell Count | 170 | 71 | 261 | 223 | 329 | 308 | 456 | 552 | 322 | 283 | 322 | 400 | 419 | 506 | 497 | 258 | 262 | 171 | 88 | 270 | 173 | 362 | 410 | |
| Labelled Cell Count | 176 | 73 | 269 | 234 | 357 | 333 | 495 | 603 | 383 | 343 | 374 | 408 | 431 | 524 | 543 | 274 | 288 | 171 | 88 | 270 | 173 | 362 | 410 | |
Yeast GFP Assignment
Protein Abundance
| Screen | WT1 | WT2 | WT3 | RAP60 | RAP140 | RAP220 | RAP300 | RAP380 | RAP460 | RAP540 | RAP620 | RAP700 | HU80 | HU120 | HU160 | rpd3Δ_1 | rpd3Δ_2 | rpd3Δ_3 | AF100 | AF140 | AF180 |
|---|---|---|---|---|---|---|---|---|---|---|---|---|---|---|---|---|---|---|---|---|---|
| Mean Cell GFP Intensity (1e-4) | 5.3 | 5.2 | 5.6 | 5.3 | 5.9 | 4.7 | 4.8 | 5.1 | 4.2 | – | 4.0 | 4.6 | 5.5 | 5.8 | 5.9 | 10.6 | 10.6 | 10.3 | 5.3 | 5.2 | 5.6 |
| Std Deviation (1e-4) | 0.6 | 0.7 | 0.7 | 0.9 | 1.2 | 1.1 | 1.0 | 0.9 | 0.8 | – | 0.6 | 0.7 | 0.7 | 0.9 | 1.0 | 1.4 | 1.3 | 1.4 | 1.1 | 1.0 | 1.0 |
| Intensity Change (Log2) | – | – | – | -0.07 | 0.07 | -0.25 | -0.21 | -0.14 | -0.4 | – | -0.5 | -0.29 | -0.02 | 0.04 | 0.07 | 0.91 | 0.92 | 0.88 | -0.09 | -0.11 | -0.0 |
Localization Change
| Localization | RAP60 | RAP140 | RAP220 | RAP300 | RAP380 | RAP460 | RAP540 | RAP620 | RAP700 | HU80 | HU120 | HU160 | rpd3Δ_1 | rpd3Δ_2 | rpd3Δ_3 |
|---|---|---|---|---|---|---|---|---|---|---|---|---|---|---|---|
| Cortical Patches | 0 | 3.1 | 0 | 0 | 0 | 0 | – | 0 | 0 | 0 | 0 | 0 | 0 | 0 | 0 |
| Bud | 0 | 0 | 0 | 0 | 0.8 | 0 | – | 0 | 0 | 0 | 0 | 0 | 0 | 0 | 0 |
| Bud Neck | 0 | 0 | 0 | 0 | 0 | 0 | – | 0 | 0 | 0 | 0 | 0 | 0 | 0 | 0 |
| Bud Site | 0 | 0 | 0 | 0 | 0 | 0 | – | 0 | 0 | 0 | 0 | 0 | 0 | 0 | 0 |
| Cell Periphery | 0 | 0 | 0 | 0 | 0 | 0 | – | 0 | 0 | 0 | 0 | 0 | 0 | 2.2 | 2.9 |
| Cytoplasm | -5.0 | -7.1 | -6.6 | -6.3 | -6.6 | -9.0 | – | -9.4 | -7.5 | -1.7 | -2.9 | -3.1 | -3.6 | -2.2 | -3.5 |
| Endoplasmic Reticulum | 0 | 0 | 0 | 0 | 0 | 0 | – | 0 | 0 | 0 | 0 | 0 | 2.3 | 0 | 2.3 |
| Endosome | 0 | 4.1 | 0 | 0 | 3.6 | 0 | – | 0 | 0 | 0 | 3.4 | 3.3 | 0 | 0 | 0 |
| Golgi | 0 | 0 | 0 | 0 | 0 | 0 | – | 0 | 0 | 0 | 0 | 0 | 0 | 0 | 0 |
| Mitochondria | 0 | 0 | 0 | 0 | 3.1 | 0 | – | 0 | 0 | 0 | 0 | 0 | 0 | 0 | 0 |
| Nucleus | 0 | 0 | 0 | 0 | 0 | 0 | – | 0 | 0 | 0 | 0 | 0 | 0 | 0 | 0 |
| Nuclear Periphery | 0 | 0 | 0 | 0 | 0 | 0 | – | 0 | 0 | 0 | 0 | 0 | 0 | 0 | 0 |
| Nucleolus | 0 | 0 | 0 | 0 | 0 | 0 | – | 0 | 0 | 0 | 0 | 0 | 0 | 0 | 0 |
| Peroxisomes | 0 | 0 | 0 | 0 | 0 | 0 | – | 0 | 0 | 0 | 0 | 0 | 0 | 0 | 0 |
| SpindlePole | 4.1 | 5.4 | 0 | 0 | 4.9 | 0 | – | 0 | 0 | 0 | 0 | 0 | 0 | 0 | 0 |
| Vacuole | 0 | 2.5 | 0 | 0 | 0 | 0 | – | 0 | 0 | 0 | 0 | 0 | 3.5 | 2.8 | 3.5 |
External localization resources
Images






























Protein Concentration and Protein Localization Data
| R1 | R2 | R3 | ||||||||||||||||
|---|---|---|---|---|---|---|---|---|---|---|---|---|---|---|---|---|---|---|
| G1 Pre-START | G1 Post-START | S/G2 | Metaphase | Anaphase | Telophase | G1 Pre-START | G1 Post-START | S/G2 | Metaphase | Anaphase | Telophase | G1 Pre-START | G1 Post-START | S/G2 | Metaphase | Anaphase | Telophase | |
| Concentration | -0.703 | 0.0406 | -0.2896 | -0.5036 | -0.8933 | -0.124 | -0.099 | 0.6595 | 0.3798 | 0.343 | -0.2211 | 0.1709 | 0.0077 | 0.8378 | 0.4584 | 0.6046 | 0.5644 | 0.3797 |
| Actin | 0.0235 | 0.0083 | 0.0073 | 0.0405 | 0.0074 | 0.0036 | 0.0301 | 0.0003 | 0.006 | 0.0517 | 0.0027 | 0.0018 | 0.0458 | 0.0002 | 0.0263 | 0.0182 | 0.0079 | 0.002 |
| Bud | 0.001 | 0.0012 | 0.0011 | 0.0007 | 0.0005 | 0.0007 | 0.0046 | 0.0006 | 0.0006 | 0.0012 | 0.0004 | 0.0004 | 0.0024 | 0.0026 | 0.0007 | 0.0006 | 0.0004 | 0.0001 |
| Bud Neck | 0.0096 | 0.0002 | 0.0032 | 0.0091 | 0.0029 | 0.0012 | 0.017 | 0.0002 | 0.0003 | 0.0026 | 0.0004 | 0.0005 | 0.0015 | 0.0005 | 0.0007 | 0.0012 | 0.0008 | 0.0005 |
| Bud Periphery | 0.0018 | 0.002 | 0.0012 | 0.001 | 0.0007 | 0.0008 | 0.0066 | 0.0002 | 0.0004 | 0.0017 | 0.0002 | 0.0009 | 0.0021 | 0.0009 | 0.0009 | 0.0005 | 0.0003 | 0.0003 |
| Bud Site | 0.0113 | 0.0012 | 0.0075 | 0.0021 | 0.0018 | 0.0002 | 0.0185 | 0.0031 | 0.0032 | 0.0045 | 0.0003 | 0.0002 | 0.0025 | 0.0192 | 0.0027 | 0.0071 | 0.0032 | 0.0002 |
| Cell Periphery | 0.001 | 0.0003 | 0.0005 | 0.0003 | 0.0003 | 0.0002 | 0.0007 | 0.0001 | 0.0002 | 0.0003 | 0.0001 | 0.0001 | 0.0003 | 0.0003 | 0.0002 | 0.0002 | 0.0001 | 0.0002 |
| Cytoplasm | 0.3379 | 0.5628 | 0.4755 | 0.3862 | 0.4885 | 0.6735 | 0.5609 | 0.8445 | 0.7673 | 0.6901 | 0.591 | 0.8078 | 0.5811 | 0.7999 | 0.6931 | 0.6707 | 0.6589 | 0.8031 |
| Cytoplasmic Foci | 0.0401 | 0.023 | 0.0358 | 0.0556 | 0.0814 | 0.0177 | 0.0581 | 0.014 | 0.0245 | 0.0419 | 0.0343 | 0.0409 | 0.0408 | 0.0145 | 0.0264 | 0.0443 | 0.0464 | 0.0192 |
| Eisosomes | 0.0008 | 0.0002 | 0.0002 | 0.0009 | 0.0001 | 0.0002 | 0.0002 | 0 | 0.0001 | 0.0008 | 0 | 0.0001 | 0.0003 | 0 | 0.0004 | 0.0001 | 0.0002 | 0 |
| Endoplasmic Reticulum | 0.0054 | 0.0033 | 0.0065 | 0.0065 | 0.0028 | 0.0023 | 0.005 | 0.0028 | 0.0041 | 0.0019 | 0.0015 | 0.0031 | 0.0111 | 0.0026 | 0.0034 | 0.0025 | 0.0043 | 0.0037 |
| Endosome | 0.0527 | 0.0269 | 0.0362 | 0.0737 | 0.116 | 0.017 | 0.0441 | 0.0105 | 0.0367 | 0.0828 | 0.134 | 0.0201 | 0.0529 | 0.0234 | 0.0305 | 0.0968 | 0.0388 | 0.0365 |
| Golgi | 0.0051 | 0.0016 | 0.0057 | 0.02 | 0.0139 | 0.0015 | 0.01 | 0.0005 | 0.0057 | 0.0136 | 0.0726 | 0.0012 | 0.0104 | 0.0005 | 0.0046 | 0.0052 | 0.0043 | 0.0021 |
| Lipid Particles | 0.0044 | 0.0012 | 0.0079 | 0.0385 | 0.0127 | 0.0022 | 0.0115 | 0.0004 | 0.0076 | 0.0018 | 0.0025 | 0.0005 | 0.0069 | 0.0002 | 0.0052 | 0.0051 | 0.0094 | 0.0033 |
| Mitochondria | 0.013 | 0.001 | 0.0116 | 0.0718 | 0.0234 | 0.0209 | 0.0123 | 0.0001 | 0.003 | 0.0267 | 0.0114 | 0.0183 | 0.0115 | 0.0002 | 0.0067 | 0.002 | 0.0014 | 0.0097 |
| None | 0.4605 | 0.3539 | 0.3679 | 0.2593 | 0.2187 | 0.2422 | 0.1604 | 0.1151 | 0.124 | 0.0556 | 0.13 | 0.0936 | 0.1891 | 0.1283 | 0.1737 | 0.1246 | 0.1523 | 0.1119 |
| Nuclear Periphery | 0.0069 | 0.0009 | 0.0023 | 0.0023 | 0.001 | 0.0054 | 0.0098 | 0.0006 | 0.0011 | 0.0009 | 0.0007 | 0.0019 | 0.0069 | 0.0006 | 0.0019 | 0.0011 | 0.0046 | 0.0006 |
| Nucleolus | 0.0011 | 0.0002 | 0.0032 | 0.0003 | 0.0012 | 0.0003 | 0.0019 | 0.0001 | 0.0005 | 0.0001 | 0.0001 | 0.0001 | 0.0004 | 0.0001 | 0.0005 | 0.0001 | 0.0013 | 0.0001 |
| Nucleus | 0.0065 | 0.0011 | 0.0026 | 0.0013 | 0.001 | 0.0011 | 0.0029 | 0.0007 | 0.0011 | 0.0013 | 0.0007 | 0.0008 | 0.0017 | 0.0008 | 0.0012 | 0.001 | 0.0061 | 0.0007 |
| Peroxisomes | 0.0037 | 0.0003 | 0.0083 | 0.0152 | 0.0091 | 0.0006 | 0.0209 | 0.0003 | 0.0028 | 0.0043 | 0.0014 | 0.0026 | 0.0148 | 0.0001 | 0.009 | 0.0042 | 0.0447 | 0.0009 |
| Punctate Nuclear | 0.0051 | 0.0004 | 0.002 | 0.002 | 0.0018 | 0.0026 | 0.0078 | 0.0003 | 0.0007 | 0.0003 | 0.0002 | 0.0009 | 0.0017 | 0.0002 | 0.0029 | 0.0007 | 0.0083 | 0.0004 |
| Vacuole | 0.0075 | 0.0088 | 0.0119 | 0.0098 | 0.0114 | 0.0046 | 0.0137 | 0.0051 | 0.0087 | 0.013 | 0.012 | 0.0032 | 0.0134 | 0.0044 | 0.0077 | 0.0116 | 0.0051 | 0.0037 |
| Vacuole Periphery | 0.0012 | 0.001 | 0.0016 | 0.0029 | 0.0033 | 0.0013 | 0.003 | 0.0006 | 0.0013 | 0.003 | 0.0034 | 0.0011 | 0.0024 | 0.0006 | 0.0014 | 0.0022 | 0.001 | 0.0008 |
Sequencing Data
| R1 | R2 | |||||||||
|---|---|---|---|---|---|---|---|---|---|---|
| G1 Post-START | S/G2 | Metaphase | Anaphase | Telophase | G1 Post-START | S/G2 | Metaphase | Anaphase | Telophase | |
| Gene Expression | 9.7052 | 4.8941 | 7.5934 | 11.1562 | 7.7435 | 11.4408 | 10.0092 | 12.6002 | 13.2337 | 14.5532 |
| Translational Efficiency | 1.1168 | 1.0864 | 0.6003 | 0.519 | 0.9365 | 1.0676 | 0.7071 | 0.4582 | 0.6259 | 0.5892 |
Hit Data
| Dataset | Hit |
|---|---|
| Protein Concentration | ✘ |
| Protein Localization | ✘ |
| Gene Expression | ✘ |
| Translational Efficiency | ✔ |
Endocytosis
| Temp | Actin Patch (Sac6-tdTomato) | Cortical Patch (Sla1-GFP) | Late Endosome (Snf7-GFP) | Vacuole (Vph1-GFP) |
|---|---|---|---|---|
| 37℃ | ||||
| RT |
Cell Cycle Omics
CYCLoPs (Atg13-GFP)
| Gene / Allele | Actin Patch (Sac6-tdTomato) | Cortical Patch (Sla1-GFP) | Late Endosome (Snf7-GFP) | Vacuole (Sac6-tdTomato) |
|---|
| Gene | Images |
|---|
| Gene | Images |
|---|
Images are not yet available
Images are not yet available